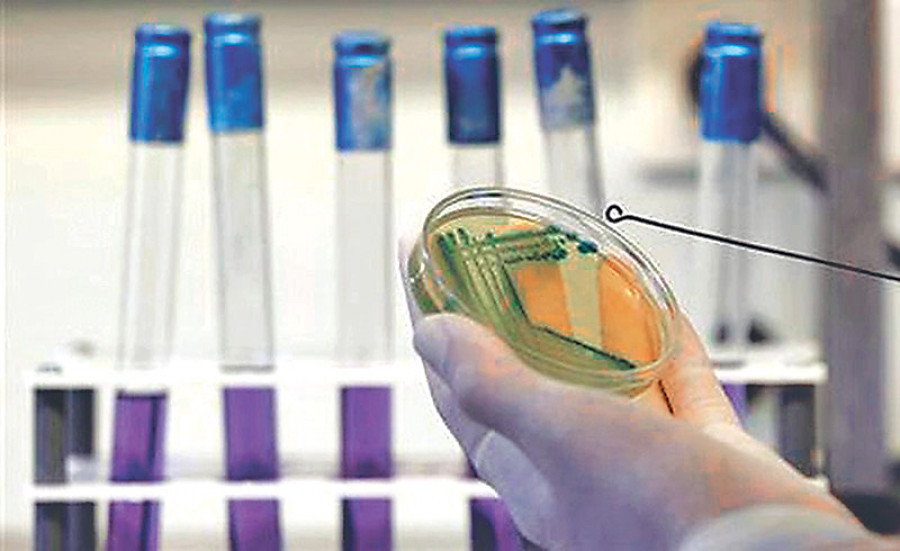

Money
Quality watchdog comes up with standards for 12 food products
The proposed standards will ensure quality and safety of food items, officials say.
Krishana Prasain
Nepal’s quality watchdog has prepared a draft of compulsory quality standards for 12 types of legumes and milk products as per the Food Act, and put them to a discussion by experts.
The 12 items are whole bean/split bean lentil, while faba bean (bakula)/split faba bean lentil, whole cowpea/split cowpea lentil, whole faba (rajma) bean/split faba bean lentil, whole pea, split pea lentil, horse gram lentil, rice bean lentil, ice-cream, frozen dessert, khuwa/kurauni, chhurpi and dairy whitener.
Mohan Krishna Maharjan, spokesperson for the Department of Food Technology and Quality Control, said the draft was prepared during a review of the first four months, and have been discussed by a technical sub-committee.
The proposed standards will go to the Food Standardisation Committee comprising the secretary of the Ministry of Agriculture and Livestock Development and concerned stakeholders from government bodies, the private sector and consumer rights activists.
Following approval by the committee, the new quality standards will be sent to the World Trade Organisation for Sanitary and Phytosanitary Measures through the Ministry of Agriculture and Livestock Development.
Maharjan said that if the World Trade Organisation does not send any notification for at least two months, they will go to the cabinet for approval and will be implemented from the date of publication in the Nepal Gazette.
“After the quality standards have been published in the Nepal Gazette, action will be taken under the Food Act against the manufacturers of products not meeting the minimum requirements,” Maharjan said.
The new standards will ensure the quality and safety of the products besides making market inspection more efficient, he added.
“We follow the internationally recognised standards contained in the Codex Alimentarius,” said Santosh Dahal, food research officer at SPS National Enquiry Point of the department.
As per the draft standards, artificial colours should not be used in lentils and legumes and they should be clean and free of harmful chemicals.
They should not contain inorganic matters like sand, dust or mud. Organic matter content like chaff or other grains should not be more than 3.0 percent.
Internal damage to lentils and legumes due to heat and fungus or damage by insects should not be more than 5 percent and 10 percent respectively. The mycotoxin (including aflatoxin) content in food products prepared from a single or mixed legumes and lentils should not be more than 20 micrograms per kilogram. If the mycotoxin content is higher, it is harmful to human health.
Food items like ice cream, frozen dessert, khuwa/kurauni, chhurpi and dairy whitener should not contain any harmful matter.
Ice cream should have the proper composition of milk, fat, yeast and protein. The chemical and microbiological parameters need to be as per the newly set standard.
Food products should have proper packaging and labelling and maintain hygiene as per the standard set by the Food Act. The maximum residue limit for 10 fruits and vegetables, and the maximum permissible limit of mycotoxin in different food items are yet to be published in the Nepal Gazette. The standards have also been submitted to the Council of Ministers.